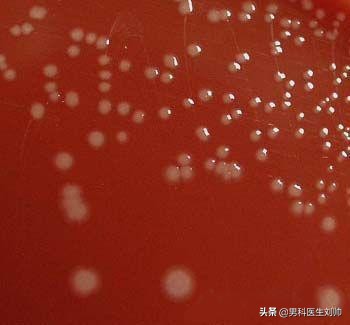
精子会寄生细菌吗,精子多种细菌混合生长

(一)溶脲脲原体(UU)
溶脲脲原体是生殖道感染的常见病原体。研究表明,UU可侵入生精细胞中,造成生精细胞结构破坏,从生精小管上脱落,其代谢产物对精子有毒副作用可破坏精子膜的完整性,精于之变性,相互融合成多核细胞,Sertoli细胞塌陷,贴壁。周葵等人实验证明,UU感染可明显抑制Sertoli细胞分泌L-1,破坏Sertoli细胞,导致其功能下降,而Sertoli细胞分泌的细胞因子IL-1是精子发生的主要调节因子,故UU感染对生精过程有较大的影响。
(二)沙眼衣原体(CT)
沙眼衣原体在*丸睾**炎患者中的检出率显著高于正常人,而*丸睾**炎等可影响精子发生,引起精子畸形,染色体异常。CT感染使男子抗精子抗体明显增高,精子质量降低。
(三)肺炎支原体(MP)
肺炎支原体会黏附于精子、损坏精子细胞。有报道弓形虫可侵入*丸睾**生殖细胞寄生、增殖,导致生精细胞分裂和坏死,干扰*丸睾**功能使生精能力下降。此外,淋病奈瑟菌、结核分枝杆菌、滴虫、白念珠菌及一些金黄色葡萄球菌、大肠埃希菌的L型感染,均可导致生精功能下降。

环境污染导致环境质量的日趋恶化,成为影响我国社会可持续发展的突出问题。揭示环境影响因素的时空分布特征和迁移转化规律,从整体、细胞和分子水平及分子流行病学调查,研究金丸精子发生与环境因素的相互关系及作用机制,是一个孕育重大突破的基础研究的前沿领域,其研究成果可为我国政府制定科学合理的环保政策、规划和保健政策提供科学决策依据,可加速我国社会的稳定持续发展和人民卫生保健水平的提高。#关注男性健康# #清风计划# #男科医生刘帅#

点击了解更多,咨询刘帅医生!
(内容源自网络,整理:刘帅团队-yishengliushuai.com)
感觉文章不错,伸伸小手点赞关注 @男科医生刘帅 ,希望更多的人了解男性知识,如有问题也可以私信,为您排忧解难!
